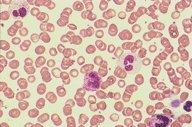

Description
This low power view of the peripheral blood shows five granulocytes,
two of which are eosinophils. The diagnosis is hypereosinophilic
syndrome, though no further diseases entity is recorded. The red
cells show some rouleaux formation.
|
|
Click on this image
to enlarge it, then
on Back buttom
in the Netscape Menu
to shrink it back down



|